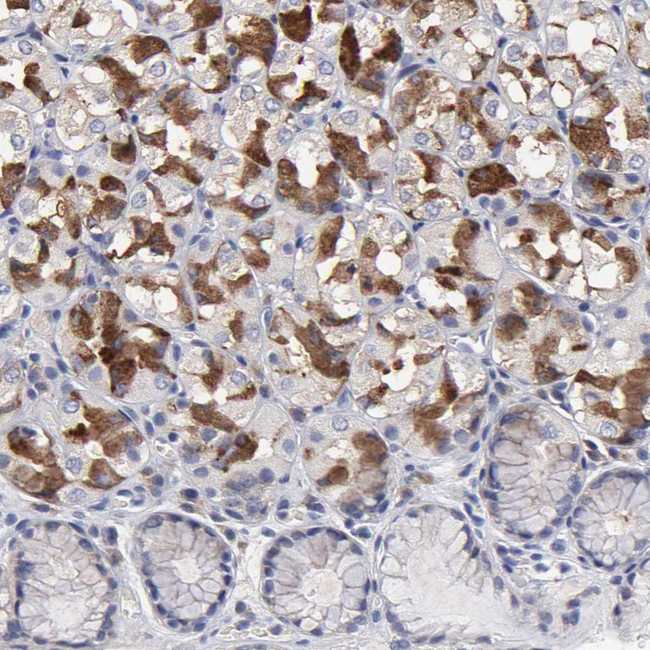
CCDC80 Antibody in Immunohistochemistry (Paraffin) (IHC (P))

Search
Invitrogen
CCDC80 Polyclonal Antibody
{{$productOrderCtrl.translations['antibody.pdp.commerceCard.promotion.promotions']}}
{{$productOrderCtrl.translations['antibody.pdp.commerceCard.promotion.viewpromo']}}
{{$productOrderCtrl.translations['antibody.pdp.commerceCard.promotion.promocode']}}: {{promo.promoCode}} {{promo.promoTitle}} {{promo.promoDescription}}. {{$productOrderCtrl.translations['antibody.pdp.commerceCard.promotion.learnmore']}}
产品信息
PA5-51695
种属反应
宿主/亚型
分类
类型
抗原
偶联物
形式
浓度
规格
纯化类型
保存液
内含物
保存条件
运输条件
RRID
产品详细信息
Immunogen sequence: MMSLLKDDVY CELAERHIQQ IVLFHQAGEE GGKVRRITSE GQILEQPLDP SLIPKLMSFL KLEKGKFGMV LLKKTLQVEE RYPYPVRLEA MYEVIDQGPI RRIEKIRQKG FVQKCKASGV EGQVVAEGND GGG
Highest antigen sequence identity to the following orthologs: Mouse - 95%, Rat - 95%.
靶标信息
CCDC80 (Coiled-Coil Domain Containing 80) is a Protein Coding gene. Diseases associated with CCDC80 include Herpes Zoster Oticus and Peripheral Nervous System Disease. Gene Ontology (GO) annotations related to this gene include heparin binding and glycosaminoglycan binding. Also, it is an estrogen regulated gene; overexpression correlates with mammary carcinogenesis.
仅用于科研。不用于诊断过程。未经明确授权不得转售。
篇参考文献 (0)
生物信息学
蛋白别名: Coiled-coil domain-containing protein 80; Down-regulated by oncogenes protein 1; long intergenic non-protein coding RNA 1279; nuclear envelope protein okuribin; similar to mouse Urb; steroid sensitive gene 1; TCONS_00006930; unnamed protein product; Up-regulated in BRS-3 deficient mouse homolog
基因别名: CCDC80; CL2; DRO1; HBE245; LINC01279; okuribin; SSG1; URB
UniProt ID: (Human) Q76M96
Entrez Gene ID: (Human) 151887